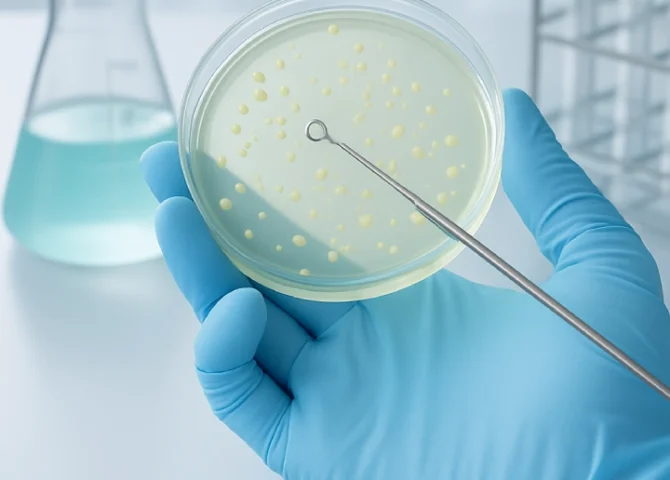

Tıbbi Cihaz Kalibrasyon Firması - Ums Medikal
İnsan ve / veya canlıların hayatlarını sürdürebilmeleri için Gıda, Hukuk ve Sağlıklı Yaşam en önemli unsurlardır.
Sağlıklı yaşamda sağlık personeli ve ilaçların büyük rolü olduğu gibi bunlara imkan veren fiziksel temiz ve steril alanlar ile teşhis ve tedavide kullanılan uluslararası standartlarda üretilmiş aktif ve pasif tıbbi cihazlar ve bunları kullanıma hazırlayan cihaz ve ekipmanların da bir o kadar önemli olduğu aşikardır.
İşte bu noktada UMS Medikal tıbbi alan ve cihazların kullanıma hazırlanmasında 2009 yılından itibaren Avrupa kuruluşları ile yaptığı işbirliği neticesinde nitelikli ve deneyimli personeli ile ulusal ve uluslararası standart ve mevzuatlara uygun yurt içi ve yurt dışında sağlık kuruluşlarının, laboratuvarların ve üreticilerin çözüm ortağı olarak hizmetler vermiş ve vermeye devam etmektedir.